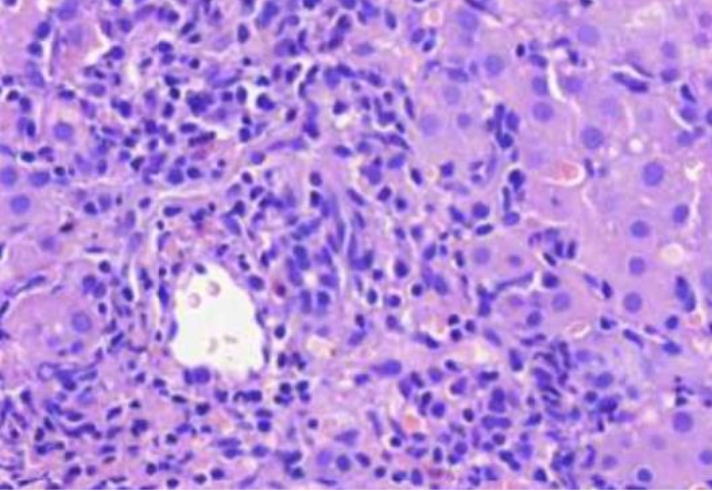
<p>M<strong><u>IKÄ TAUTI?</u></strong> tulehdussoluinfiltraation vuoksi laajentunut portaalialue, portaalialueen reuna on epätarkkarajainen, koska tulehdussolut työntyvät hepatosyyttien väliin maksalobuluksen puolelle, tästä voidaan päätellä, että tulehdus on aktiivinen</p>
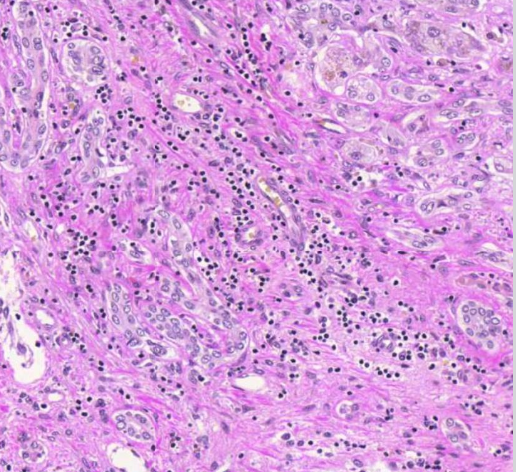
<p>sappitieproliferaatiota ja lievää lymfosyyttilisää</p>

patalogia II mikroskopia 1/2
1/23
There's no tags or description
Looks like no tags are added yet.
Name | Mastery | Learn | Test | Matching | Spaced | Call with Kai |
|---|
No analytics yet
Send a link to your students to track their progress
24 Terms
ei-alkoholiperäinen rasvamaksatauti
MIKÄ TAUTI? patologista hepatosyyttien steatoosia (rasvoittumista)

ei-alkoholiperäinen rasvamaksatauti
MIKÄ TAUTI? Portaali-alueella nähdään tulehdussolukertymää ja sidekudoslisää

krooninen hepatiitti
MIKÄ TAUTI? lobulusten puolella pieniä tulehdussoluinfiltraatteja hepatosyyttien välissä, osassa hepatosyyteistä rasvapisaroita, tämä löydös sopii lievään rasvadegeneraatioon, joka on tyypillistä krooniselle c-hepatiitille

krooninen hepatiitti
MIKÄ TAUTI? tulehdussoluinfiltraation vuoksi laajentunut portaalialue, portaalialueen reuna on epätarkkarajainen, koska tulehdussolut työntyvät hepatosyyttien väliin maksalobuluksen puolelle, tästä voidaan päätellä, että tulehdus on aktiivinen
krooninen kolekystiitti
MIKÄ TAUTI? Sappirakon seinämä on paksuuntunut ja villusmaiset rakenteet ovat melko epäsäännöllisiä. Seinämässä on runsasta tulehdussolulisää

rokitansky-aschoffin sinuksisksi
kohonneen paineen vuoksi seinämä on paikoin työntynyt lihaskerroksen lomaan syviksi poimuiksi, näitä kutsutaan <mikä nimi>, sen ympärillä havaitaan myös tulehdussolulisää (vinkki: krooninen kolekystiitti)

lievää fibroosia
mitä kuvassa näytetään? (vinkki: krooninen kolekystiitti)

krooninen kolekystiitti
MIKÄ TAUTI? lymfaattiset solut muodostavat paikoin reaktiokeskuksia

sidekudosseptoja, joiden välissä nodulaarista regeneraatiota
mitä kuvassa näkyy yleisesti ja millainen regeneraatio? (vinkki: maksaskirroosi)

hydrooppista hepatosyyttien degeneraatiota
millaista degeneraatiota kuvassa näkyy? (vinkki: maksaskirroosi)

sappistaasia
mitä on hepatosyyttien välissä? (vinkki: maksaskirroosi)

maksaskirroosi
sappitieproliferaatiota ja lievää lymfosyyttilisää
Diabeettinen nefropatia
mikä tauti on kyseessä? Päättele kuvista ja tekstistä

Lievää lymfosyyttikertymää interstitiumissa.
mitä kuvassa näkyy? (vinkki: onkosytooma)

onkosytooma
MIKÄ TAUTI? Kasvainsolujen tumat ovat pyöreitä. Sytoplasmaa on runsaasti, ja se on osin rakeista ja granulaarista.

Kirkassoluinen munuaiskarsinooma
MIKÄ TAUTI? Kasvaimen vaskulaari-invaasiota perirenaalisessa rasvakudoksessa.

Kyhmystruuma
MIKÄ TAUTI? Kilpirauhanen muodostuu epäsäännöllisen muotoisista kyhmyistä. Follikkeliepiteeli on solu- ja tumarakenteeltaan säännöllistä. Follikkelit sisältävät kolloidia.

akuutti pankreatiitti
päättele kuvista, mikä tauti on kyseessä?

lipooma
katso kuvia ja tekstejä, mikä tauti on kyseessä?

koagulaationekroosia
mitä nähdään tuumorin alueella? (vinkki: liposarkooma)

Liposarkooma
päättele kuvan avulla, mikä tauti on kyseessä?

Aktiinikeratoosi
päättele kuvien ja tekstien avulla, mikä tauti on kyseessä?

Dysplasiaan
mihin viittaavat seuraavat mitoosit? (vinkki: aktiinikeratoosi)

Huulen levyepiteelikarsinooma
seuraavan kuvan ja tekstien avulla, mikä tauti on kyseessä?
